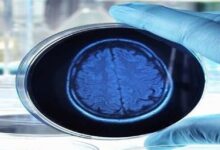

أطعمة لا ينبغي تناولها مع الشاي أو القهوة أبدا

وقالت الصيدلانية ديبورا غرايسون، إن شرب الشاي أو القهوة مع أطعمة معينة، مثل اللحوم الحمراء والخضروات الورقية الخضراء (السبانخ والبروكلي)، قد يزيد من فرصة الإصابة بنقص شديد في العناصر الغذائية.
وأوضحت أن المواد الكيميائية الموجودة في هذه المشروبات الساخنة، تمنع الجسم من امتصاص الحديد (المعدن الحيوي لنقل الأكسجين في جميع أنحاء الجسم، ما يمنحنا الطاقة ونظام مناعة قوي).
وتابعت غرايسون: “إذا كنت تشرب الشاي دائما مع وجبتك الغذائية، فقد تصاب بفقر الدم”.
ويمكن أن تكون أعراض فقر الدم منهكة، بما في ذلك الإرهاق الشديد وتساقط الشعر والالتهابات المتكررة.
وتقول: “إن وجود السوائل في المعدة يمكن أن يقلل من كمية الطعام التي يمكنك تناولها”.
وتشمل نصائح غرايسون الأخرى: تناول الطعام في موعد لا يتجاوز 3 ساعات قبل الذهاب إلى الفراش، والامتناع عن الاستلقاء بعد الوجبة لتجنب أعراض الارتجاع. (روسيا اليوم)
مصدر الخبر
للمزيد Facebook